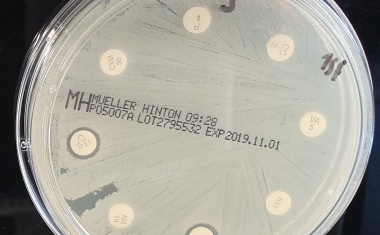
Photo

Strategien im Kampf gegen spezifische Antibiotikaresistenzen
Einsatz von Carbapenemen sichern: Prof. Linda Falgenhauer vom Institut für Hygiene und Umweltmedizin der Universität Gießen ist Mitglied der internationalen AEPIC-Allianz
Einsatz von Carbapenemen sichern: Prof. Linda Falgenhauer vom Institut für Hygiene und Umweltmedizin der Universität Gießen ist Mitglied der internationalen AEPIC-Allianz

